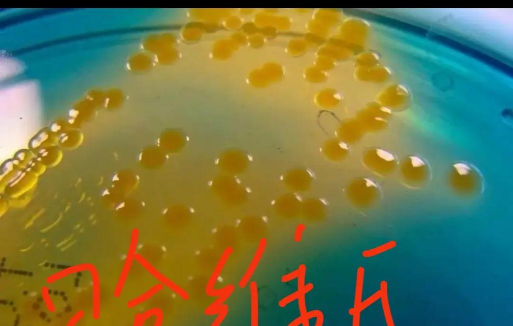
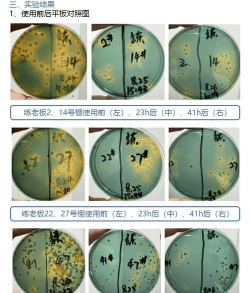

畜牧热门
花卉热门
水产热门
园林热门
水产养殖弧菌是什么菌群
水产养殖中提到的“弧菌”是指一类具有特定生物学特性的细菌,其特点和危害可归纳如下:
一、基本特性形态特征
弧菌属细菌以菌体短小、弯曲成弧形、尾部带鞭毛为典型特征,属于革兰氏阴性菌,无芽胞。
生长环境
适应温度10-35℃,最适25℃;偏好低氧环境,常寄生于水体底泥、残饵、粪便等中。
种类与致病性
包含副溶血弧菌、溶藻弧菌、哈维氏弧菌、霍乱弧菌等,其中副溶血弧菌是水产养殖中危害最大的病原菌。
二、对水产养殖的危害疾病表现
弧菌感染可导致鱼虾肝胰脏坏死、空肠空胃、烂尾病等,严重时引发死亡。对虾养殖中,弧菌是头号杀手,可导致早期肝胰腺坏死。
爆发特点
发病具有季节性,多集中在4-6月高温期;传播途径包括水体污染、设备交叉感染等。
三、防控措施环境管理
- 保持水质清洁,定期检测pH值(6-8.5)、盐度(5‰-30‰)。
- 清除底泥中的残饵、粪便等污染源,减少弧菌滋生环境。
生物防治与药物
- 使用噬菌体(如优弧灵)针对性杀灭弧菌。
- 配合使用抗生素(如氟喹诺酮类)预防感染,但需避免抗药性产生。
养殖管理
- 避免过度密植,降低应激反应;及时淘汰病体虾,减少传播风险。

- 换水时注意温差,避免水体剧烈波动引发感染。
四、其他注意事项弧菌部分种类(如溶藻弧菌)可污染人类食物,养殖场需严格遵守卫生规范,防止交叉污染。
发现疫情后需及时隔离病区,采用高温消毒(60℃以上)处理受污染水体和设备。
通过综合管理措施,可有效控制弧菌感染,保障水产养殖效益。
猜你喜欢内容
-
水产小龙虾的养殖技术
水产小龙虾养殖需结合科学管理、环境优化和精细操作,具体可分为以下关键环节:池...
-
水产养殖怎么知道缺氮磷
水产养殖中判断缺氮磷的方法需结合水质监测和植株表现综合分析,具体如下:叶片发...
-
水产养殖合作社成员要求
水产养殖合作社的人员要求需结合法律规范与行业实际,主要包含以下要点:成员数量 ...
-
水产养殖上有哪些消毒药
水产养殖中常用的消毒剂种类繁多,根据化学成分和作用机制可分为以下几类,并附上...
-
办水产养殖证去哪里办
办理水产养殖证明的机构及流程如下:水产养殖证明需向 当地人民政府渔业行政主管部...
-
单硅酸在水产养殖中作用
单硅酸在水产养殖中具有多重作用,综合多个权威资料可归纳为以下核心功能:改底促...
-
小屋水产养殖基地在哪里
根据天眼查信息,重庆市渝北区小屋水产品养殖有限公司的注册地址为 重庆市渝北区古...
-
水产养殖怎么培藻肥水的
水产养殖中培藻肥水需要综合考虑水质、温度、光照等环境因素,并选择合适的肥料、...
-
常宁有多少水产养殖基地
根据搜索结果,常宁市水产养殖场地的总面积为 7.62万亩,具体信息如下:宜元村依托...
-
水产养殖用什么醋酸钠
水产养殖用醋酸钠是一种多功能化学物质,其应用价值主要体现在以下几个方面:常规...
农业知识▪优秀内容



